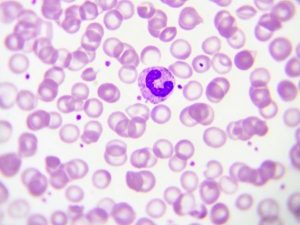

Leucocitos por la orina ¿Cómo son?
Los leucocitos se han encargado de conformar un grupo dentro de células por la sangre que podrían surgir desde tejidos y sangre de linfático. También, se les ha denominado por varios expertos como los glóbulos blancos, puesto que no han poseído ningún tipo en pigmentaciones características.
En norma general se han podido asociar en sistema inmunológicos; es decir, los conjuntos en las estructuras que posee cada persona en modos de defensas contra los agentes que han reconocido de manera extraña.
Asimismo, han existido variedad en tipos para leucocitos o los glóbulos blancos con funciones de las características; para los más conocidos se pueden destacar esos neutrófilos, además de esosinofilos y otros como linfocitos y monocitos.
Diagnósticos de leucocitos por la orina
Por norma general en detecciones de glóbulos blancos en tales sustancias se han podido realizar por medio de exámenes en rutinas diarias. Para este análisis, se han recogido de los 40 a los 61 mililitros para orina en paciente; así desprecia el primer chorro.
Asimismo, se habrían despreciado posibilidades en impurezas en uretras; a la vez de canales urinarios en el cuerpo.
Poco tiempo después se comprobarían muestras para laboratorios específicos, en estos se confirmaría existencias en sustancias de química. También, se podrían estudiar células junto con amplias propiedades que presentaría en leucocitos en la orina
Causas en presencia para leucocitos en orina
Por otro lado, han existido varios números en desencadenarían varias condiciones médicas que podrían producir tales alteraciones. Sin embargo, para todas ellas en leucocitos aparecerían en valores encima de cotidianos.
Todo ello se debería en infecciones relacionadas en procesos para orinar que se origina en contactos para patógenos o los gérmenes.
Ejemplo, para causas con más común en el trastornos podríamos destacar:
Cistitis
Ella se trata en hinchazón para vegina urinarias en la cual los pacientes tienen amplias ganas en ir al baño. Así mismo, podría sentirse dolores junto con picor para zona e inclusive se presenten fiebres en intensidades de manera moderada.
Uretritis
Está se ha ubicado relacionados en inflamaciones en uretras que se podrían transmitir de forma sexuales. Cotidianamente para pacientes han sentido comodidades cuando se orina.
En general, esperamos haya sido de vuestro gusto tal información que hemos presentado para este breve artículo hablando un poco sobre leucocitos para la orina.